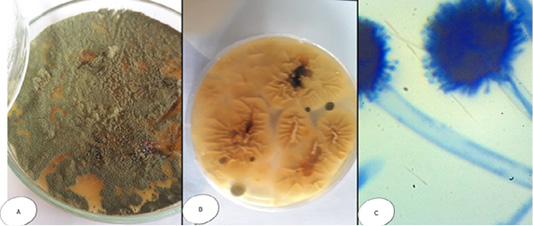
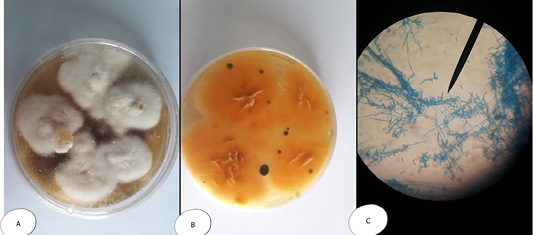
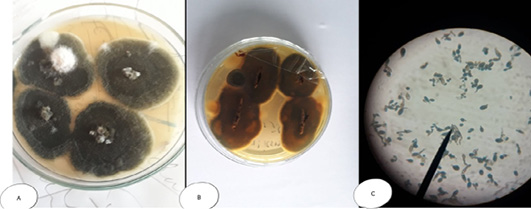

Advances in Animal and Veterinary Sciences
Aphanomyces invadans (A) Petri dish Surface side (B) Petri dish reverse side - with the characteristic white transparent velvet surface (become heavy and opaque at 7th day on SDA). (C) hyphae stained with LCB give non septated branched hyphae with cytoplasmic organelles, the branches of hyphae give y- shape.
Aspergillus flavus (A) Petri dish…Surface side (B) Petri dish reverse side (C) hyphae stained with LCB showing characteristic typical head.
Aspergillus niger (A) Petri dish Surface side (B) Petri dish….reverse side (C) hyphae stained with LCB showing characteristic round head with black conidia.
Penicillium sp. (A and B) Petri dish on SDA with different colour and texture. (C) hyphae stained with LCB showing characteristic brush- like arrangement.
Fusarium sp. (A) Petri dish Surface side (B) Petri dish reverse side (C) hyphae stained with LCB showing characteristic snow white colonies with rose pigment in the center.
Mucor sp. (A) Petri dish…Surface side (B) Petri dish reverse side (C) hyphae stained with LCB showing characteristic round sporangia.
Alternaria sp. (A) SDA Petri dish Surface side showing grayish brown to green color (B) Petri dish reverse side (C) hyphae stained with LCB showing characteristic septated hyphae with dark branched condiophores producing two or more branching tree-like with oval condia having velvety dull gray colour under microscope.
Agarose gel electrophoresis for PCR products representing amplification of 569 bp of inter-transcribed spacer (ITS) gene in Aphanomyces invadans. Lane 1: 100 bp DNA Ladder. Pos.: is control positive; Neg.: is control Negative; Lane 1, 2 and 3: positive sample.
Agarose gel electrophoresis for PCR products representing amplification of 595 bp of inter-transcribed spacer (ITS) gene in Asperigillus flavus and 600 bp Asperigillus niger. Lane 1: 100 bp DNA Ladder; Pos.: is control positive; Neg.: is control Negative; Lane 1: positive sample for Asperigillus flavus; Lane 2: positive sample for Asperigillus niger.